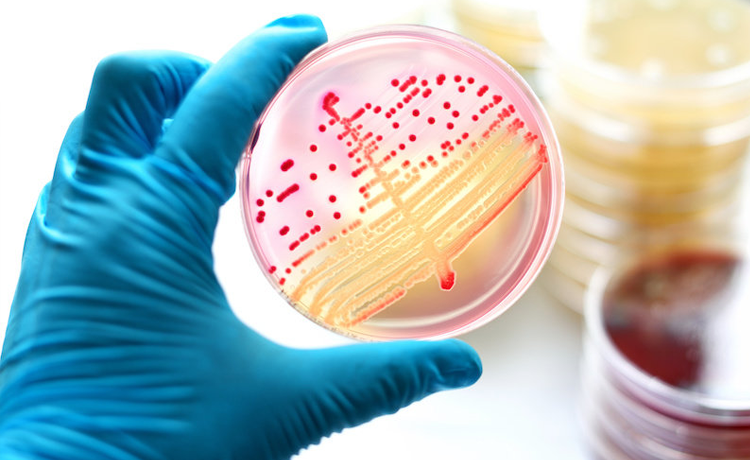

Gonore hastalığı ‘’Neisseria Gonorrhoeae’’ olarak bilinen bir çeşit bakterinin neden olduğu cinsel rahatsızlıktır. Bakterinin vücuda alınmasından itibaren 4-6 gün içerisinde genellikle belirtilerini gösterebilmektedir. Dünyada en yaygın cinsel rahatsızlıklardan biri haline gelen Gonore hem kadın hem erkeklerde görülebilen bir hastalıktır.
Özellikle de erkeklerde daha sık görülen bel soğukluğu, en sık 15-24 yaş aralığındaki gençlerde görülmektedir. Gonore bakterileri, üreme sisteminde rahim (Serviks), penis ve idrar yolları (Üretra) bölgesinde kolayca çoğalabilen bir bakteri türüdür. Tedavi edilmediği takdirde hem kadın hem erkeklerde kısırlık ve eklem hastalıkları gibi ciddi rahatsızlıklara yol açan hastalığın, en kısa sürede uzman bir doktor kontrolünde tedavi edilmesi oldukça önemlidir.
Gonore hastalığı da cinsel yolla bulaşan diğer hastalıklarda olduğu gibi cinsel temas yolu ile bulaşmaktadır. Neisseria Gonorrhoeae bakterisini taşıyan hasta ile anal, oral ve vajinal bölgelerin teması sırasında bulunduğu bölgeye yerleşen bakteriler, 4-6 gün kuluçka dönemini yaşamaktadır. Bakterinin en çok bulaşıcı olduğu dönem de tam olarak bu kuluçka dönemidir. Bakterinin kuluçka dönemi genellikle 1 hafta içinde biter ve hastada gözle görülür belirtiler ortaya çıkmaya başlar.
Gonore enfeksiyonu, bakteriyi taşıyan gebeden doğum sırasında bebeğe de bulaşabilmektedir. Bebeğe geçen bakteri genellikle göz bulguları ile kendini ortaya çıkarır. Gonore geçirmiş ve tedavi olmuş kişilerin daha sonradan bakteriyi yeniden kapma ihtimali de bulunmaktadır. Gonore enfeksiyonundan korunmak için düzenli doktor kontrolünde olmak, çoklu partnerden kaçınmak, cinsel ilişki sırasında lateks kondom kullanmak gibi önlemlerin alınması gerekmektedir.
Gonore ya da halk dilinde Bel soğukluğu hastalığının belirtileri genellikle kadınlarda ve erkeklerde farklılıklar göstermektedir. Bakteri vücuda alındıktan yaklaşık 1 hafta sonra gözle görülür belirtilerin ortaya çıktığı hastalıkta, kişilerin bağışıklıklarına göre uzun süreler belirtilerin ortaya çıkmadığı da görülmüştür. Ancak genellikle şüpheli cinsel temastan 3 ila 6 gün sonrasında belirtiler ortaya çıkmaktadır. Gonore belirtileri daha çok genital bölge ve çevresinde ortaya çıksa da eklemler, göz, boğaz ve rektum gibi vücudun diğer bölgelerinde de rahatsızlıklara sebebiyet verebilmektedir.
Erkeklerde Bel Soğukluğu (Gonore) Belirtileri Nelerdir?
Kadınlarda Bel Soğukluğu (Gonore) Belirtileri Nelerdir?
Gonore ile ilgili en çok merak edilen sorular arasında ‘’Gonore kendiliğinden geçer mi? Gonore kan tahlilinde çıkar mı?’’ gibi hastalığın tedavisine yönelik sorular da yer almaktadır. Gonore, bakteriyel bir rahatsızlık olduğu için tedavisi de antibiyotikler ile sağlanmaktadır. Bakteri, gerekli antibiyotik tedavi yapılmadığı takdirde vücuttan atılamayacağı için ilaç tedavisi görülmesi hastalığın ilerlememesi için oldukça mühimdir. Belirtilerin görüldüğü hastalarda Gonore testi, genital bölgeden kültür örneği alınarak ya da idrar testi ile yapılmaktadır.
Daha sonra doktorun belirlediği antibiyotik ilaçlar ile Gonore tedavisine başlanır. Ancak Gonore enfeksiyonu ileri aşamalarda vücudun diğer bölgelerine hasarlar verebilir ve antibiyotik tedavisi bu hasarları onarmaz. Antibiyotik tedavisi Gonore’ye neden olan bakteriyi vücudunuzdan atmanız için gerekli olan bir tedavi yöntemidir. Hastanın iyileşebilmesi için doktorun önerdiği ilaç dozuna uyması, kontrollerini düzenli bir şekilde yaptırması gerekmektedir.
Makalenin Yazarı: Jin. Op. Dr. Korkut Arslan
HPV Genital Siğil Hakkında Sıkça Sorulan Sorular
Bu sitede yer alan bilgiler, kişileri bilgilendirmek amacıyla hazırlanmış olup, hiç bir şekilde hastalıkların tanı veya tedavisinde kullanılamazlar. Sitemiz Sağlık Bakanlığı 15/2/2008 tarih ve 26788 numaralı yönetmeliği 29. maddesine göre sunduğumuz hizmet ile ilgili konularda bilgilendirme amaçlı tanıtım ve ilan kapsamında hazırlanmıştır.
Gizlilik İlkesiHPV Genital Siğil Konusunda Bilgi Alın